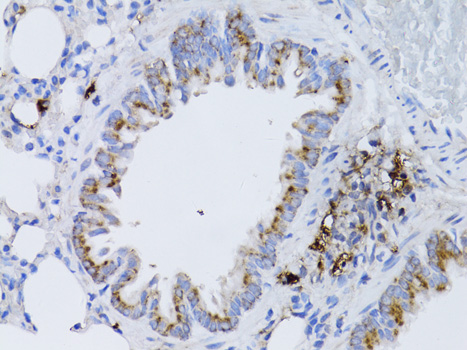
Immunohistochemistry - RARA Polyclonal Antibody

-
Product Name
RARA Polyclonal Antibody
- Documents
-
Description
Polyclonal antibody to RARA
-
Tested applications
WB, IHC, IF
-
Species reactivity
Human, Mouse, Rat
-
Alternative names
RARA antibody; NR1B1 antibody; RAR antibody; retinoic acid receptor alpha antibody
-
Isotype
Rabbit IgG
-
Preparation
Antigen: Recombinant fusion protein containing a sequence corresponding to amino acids 1-457 of human RARA (NP_001019980.1).
-
Clonality
Polyclonal
-
Formulation
PBS with 0.02% sodium azide, 50% glycerol, pH7.3.
-
Storage instructions
Store at -20℃. Avoid freeze / thaw cycles.
-
Applications
WB 1:500 - 1:2000
IHC 1:50 - 1:100
IF 1:50 - 1:100 -
Validations

Western blot - RARA Polyclonal Antibody
Western blot analysis of extracts of various cell lines, using RARA antibody at 1:1000 dilution.Secondary antibody: HRP Goat Anti-Rabbit IgG (H+L) at 1:10000 dilution.Lysates/proteins: 25ug per lane.Blocking buffer: 3% nonfat dry milk in TBST.Detection: ECL Basic Kit .Exposure time: 60s.
Immunohistochemistry - RARA Polyclonal Antibody
Immunohistochemistry of paraffin-embedded rat lung using RARA antibody at dilution of 1:100 (40x lens).

Immunohistochemistry - RARA Polyclonal Antibody
Immunohistochemistry of paraffin-embedded rat brain using RARA antibody at dilution of 1:100 (40x lens).

Immunohistochemistry - RARA Polyclonal Antibody
Immunohistochemistry of paraffin-embedded mouse brain using RARA antibody at dilution of 1:100 (40x lens).

Immunohistochemistry - RARA Polyclonal Antibody
Immunohistochemistry of paraffin-embedded mouse cerebellum using RARA antibody at dilution of 1:100 (40x lens).
-
Background
Receptor for retinoic acid. Retinoic acid receptors bind as heterodimers to their target response elements in response to their ligands, all-trans or 9-cis retinoic acid, and regulate gene expression in various biological processes. The RXR/RAR heterodimers bind to the retinoic acid response elements (RARE) composed of tandem 5'-AGGTCA-3' sites known as DR1-DR5. In the absence of ligand, the RXR-RAR heterodimers associate with a multiprotein complex containing transcription corepressors that induce histone acetylation, chromatin condensation and transcriptional suppression. On ligand binding, the corepressors dissociate from the receptors and associate with the coactivators leading to transcriptional activation. RARA plays an essential role in the regulation of retinoic acid-induced germ cell development during spermatogenesis. Has a role in the survival of early spermatocytes at the beginning prophase of meiosis. In Sertoli cells, may promote the survival and development of early meiotic prophase spermatocytes. In concert with RARG, required for skeletal growth, matrix homeostasis and growth plate function (By similarity).
Related Products / Services
Please note: All products are "FOR RESEARCH USE ONLY AND ARE NOT INTENDED FOR DIAGNOSTIC OR THERAPEUTIC USE"
